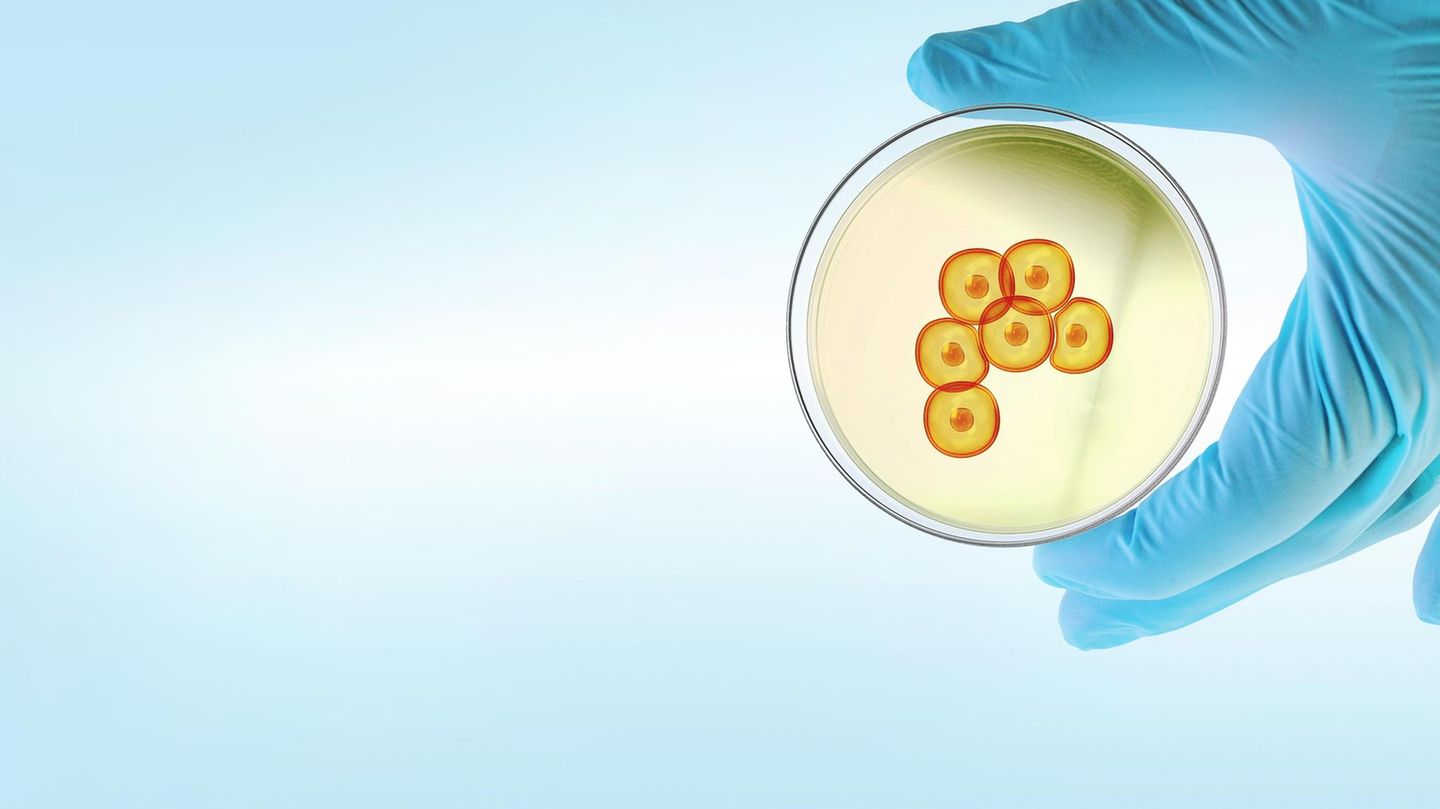
Stammzellforschung: Stammzellen (in dieser Foto-Illustration stark vergrößert) haben die Fähigkeit, sich unbegrenzt zu teilen und in unterschiedliche Körperzellen – etwa Muskel- oder Netzhautzellen – zu entwickeln. Daher gelten sie als Wunderwaffe beim Wiederaufbau von zerstörtem Gewebe Stammzellen (in dieser Foto-Illustration stark vergrößert) haben die Fähigkeit, sich unbegrenzt zu teilen und in unterschiedliche Körperzellen – etwa Muskel- oder Netzhautzellen – zu entwickeln. Daher gelten sie als Wunderwaffe beim Wiederaufbau von zerstörtem Gewebe

Der menschliche Körper, das mag man nicht wahrhaben wollen, ist ein Ort des Niedergangs. Denn die Bausteine, aus denen Knochen, Muskeln und Organe bestehen, nutzen sich ab. Permanent gehen Zellen des Körpers zugrunde. Allein in der Haut verschleißen Tag für Tag fast eine Milliarde Zellen. Und jene schleimige Schicht, die unseren Dünndarm auskleidet und vor allem für die Aufnahme von Nährstoffen zuständig ist, stirbt innerhalb von ein bis drei Tagen sogar vollständig ab.
Nicht anders ergeht es den Stoffen in unserem Blut: Mehr als 200 Milliarden rote Blutkörperchen versagen täglich ihren Dienst. Auf ihrer Reise durch Arterien, Venen und winzige Gefäße nutzen sie sich irgendwann so stark ab, dass sie keinen Sauerstoff mehr transportieren können und in der Leber zersetzt werden. Doch der Körper arbeitet gegen seine eigene Zerstörung an. Im Verborgenen sorgt ein komplexer Mechanismus dafür, dass er gerade so viel Leben erschafft, wie in gleicher Zeit vergeht. Stunde um Stunde erneuert und repariert sich unser Körper selbst. Bildet Hautzellen, die er aus unteren Lagen laufend nach oben schiebt, schwemmt Millionen neue Blutzellen in Adern und Gefäße, versieht die fast 40 Quadratmeter große innere Oberfläche des Dünndarms mit neuen Zellen.
Alle ein bis drei Tage ersetzt er die zierlichen Bläschen in unserer Lunge, in nicht einmal zwei Wochen tauscht er die Sehstäbchen in unseren Augen aus, und manches stark beanspruchte Knochenareal bildet er alle vier Monate neu. In nur einem Jahr stellt unser Körper auf diese Weise gewissermaßen sechs neue Harnblasen, acht Luftröhren, 18 Lebern, 25 Hautabdeckungen, 192 Magenausgänge her – und bildet im Verlauf eines Lebens Tausende Mal mehr neue Zellen, als die Milchstraße Sterne zählt.
Hoffnungsträger: Wissenschaftler forschen zu neuen Therapien mit Stammzellen
Das Geheimnis dieser verblüffenden Reparatur und Erneuerung liegt in einem besonderen Zelltyp: den Stammzellen. Sie sind eine Art universelles Werkzeug, denn zum einen sind sie in der Lage, sich unbegrenzt zu teilen und immer neue Zellen hervorzubringen. Zum anderen entwickeln sich aus Stammzellen die mehr als 200 verschiedenen Zellarten des menschlichen Körpers. Aus ihnen können unter anderem Haut-, Muskel-, Blut- oder Nervenzellen hervorgehen. Sie werden immer dann aktiviert, wenn der Körper irgendwo Schaden nimmt oder einzelne Zellen ersetzt werden müssen. Kommt es etwa zu einem Defekt in der Haut, erzeugen die dortigen Stammzellen durch Teilung neue Zellen, die dann in die benötigte Form ausreifen. Botenstoffe beeinflussen, ob sich eine Blutstammzelle beispielsweise zu einer Antikörper produzierenden Abwehrzelle oder zu einem Sauerstoff transportierenden roten Blutkörperchen entwickelt.